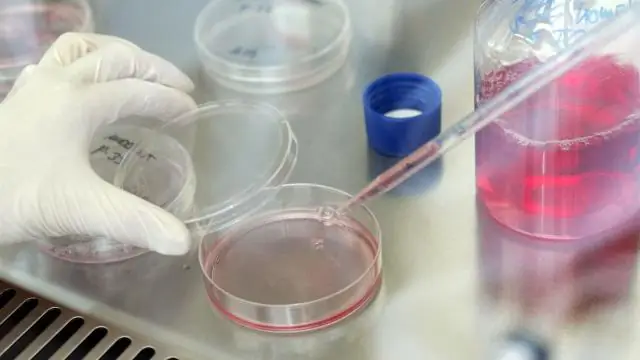
Насколько толстая кора у секвойи?

В лай гиганта секвойя это одна из его самых привлекательных черт. Он красивого красно-коричневого цвета, имеет мягкую волокнистую структуру и рифлен в виде длинных вертикальных пластин, которые придают дерево столбчатый вид. В лай возле базы старых деревья часто от 6 до 10 дюймов толстый, и может быть даже 2 фута толстый.
Также знаете, какова толщина коры у красного дерева?
Кора красного дерева мягкие, волокнисто-волокнистые, от красно-коричневого до сероватого цвета. На зрелом деревья он может вырасти до 60 сантиметров (2 фута) в толщина. В толстая кора защищает дерево от повреждений огнем.
Во-вторых, секвойя - это красное дерево? Секвойи (Секвойя sempervirens) и Секвойи (Sequoiadendron giganteum) очень разные деревья. Дерево каждого из них может быть красным, и оба конуса могут быть маленькими, у обоих есть очень высокие образцы, но они очень разные. Секвойи прибрежные - в первую очередь северное побережье Калифорнии.
Следовательно, возникает вопрос, какой толщины ствол Дерева Генерала Гранта?
Шерман Дерево самый большой, потому что он содержит самый большой объем древесины из всех дерево на земле. По оценкам, в 1987 году он насчитывал 52 508 кубических футов древесины. В Общее дерево грантов имеет самый большой сундук диаметр на 40,3 фута.
Что особенного в деревьях секвойи?
Гигант секвойи одни из самых выносливых в мире деревья. Их толстая кора делает их огнестойкими, а также устойчивыми к грибковой гнили и жукам-древоточцам.